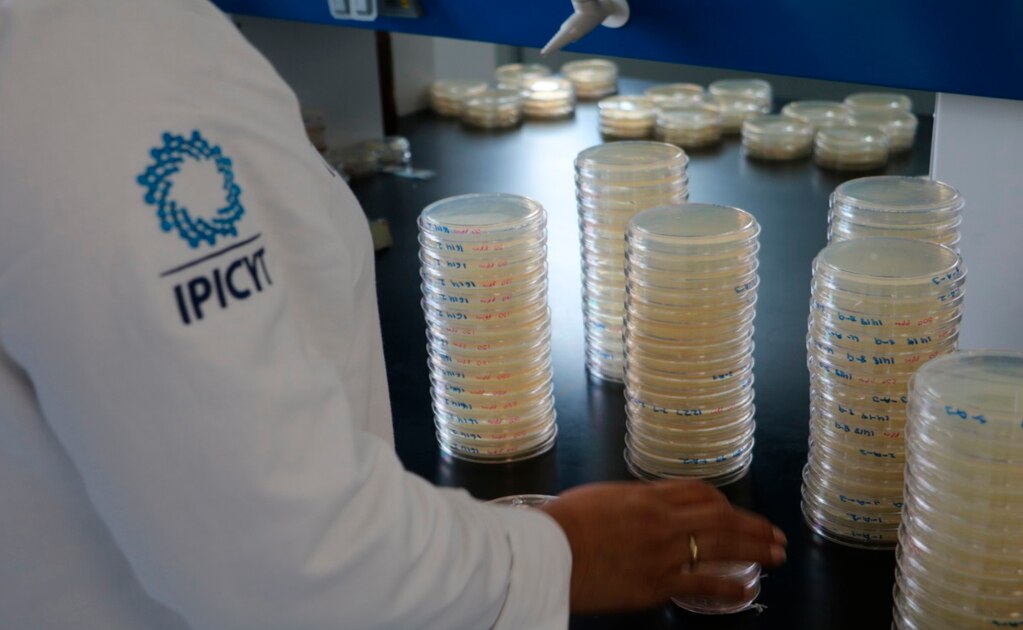
Estima investigadora que suelo es una biofarmacia productora de antibióticos naturales

El presidente de la AMC dijo que si se toma en cuenta la inflación, se estaría recibiendo el mismo presupuesto que del año anterior.
Estima investigadora que suelo es una biofarmacia productora de antibióticos naturales
Un 60% de los antibióticos en el mercado provienen de fuentes naturales.

Presentan avances científicos en materiales a base de carbono.

Algunos contaminantes se relacionan con la propagación de la influenza.

Signan convenio ambas instancias.

Innovaciones para el desarrollo de alimentos funcionales para la salud se analizan en este foro.

778 científicos se han graduado del instituto.

Jóvenes estudiantes podrán interactuar con destacados investigadores.

El congreso reúne a expertos en áreas de impacto en la salud de la contaminación del aire, derechos humanos, monitoreo atmosférico, creación de marcos normativos en la gestión de calidad del aire en la zona metropolitana de SLP.

Genera cultivos más grandes y más resistentes.






















